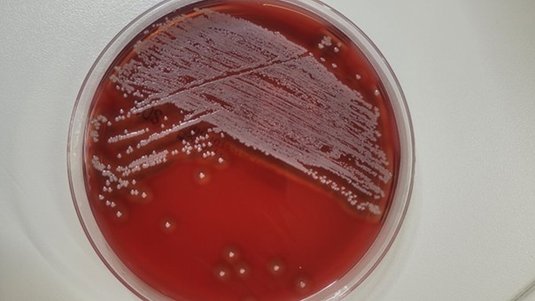

Mikrobiologische Diagnostik
- Patricia Ley
- 3 Teile | 41 Min. insgesamt
- MFA
- Teilnahmebescheinigung
In dieser 3-teiligen Serie erhalten Sie einen kompakten Überblick über mikrobiologische Untersuchungen im Wundmanagement. Sie erfahren, wann eine mikrobiologische Diagnostik sinnvoll ist und welche Bedeutung sie für die Beurteilung von Wundinfektionen hat. Außerdem lernen Sie das grundlegende Vorgehen bei mikrobiologischen Untersuchungen kennen und verstehen die wichtige Rolle der Präanalytik, insbesondere bei Probenentnahme, Transport und Verarbeitung. Abschließend zeigt Ihnen die Serie, wie Sie geeignete Untersuchungsmethoden indikationsgerecht auswählen und welche Nährmedien in der mikrobiologischen Diagnostik eingesetzt werden.